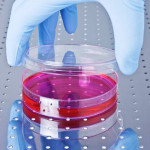

Новости о пластической хирургии
-
Вторник, 22 января 2013 года1 февраля общественности станут известны имена лучших пластических хирургов, названия лучших клиник пластической хирургии, центров косметологии, стоматологических клиник, фитнес-клубов...
-
Среда, 16 января 2013 годаКитайские мультипликаторы создали иронический ролик про девушку-барби из Одессы Валерию Лукьянову, больше известную как Аматуе. Вместе с ней под насмешки креативщиков из Поднебесной попала и ее подруга Ольга...
-
Пятница, 11 января 2013 года19-летняя участница телепроекта «Дом-2» Варвара Третьякова увеличила губы и имплантировала специальные нити в область лба, чтобы приподнять брови и «приоткрыть» взгляд.
-
Четверг, 20 декабря 2012 годаВрачи с помощью липосакции делают забор жира из тела пациента, отделяют стволовые и регенеративные клетки от жировых и пересаживают их на поврежденные участки.
-
Четверг, 15 ноября 2012 годаЕй знак был свыше дан. Британка Найлин Намита перевоплотилась в Нефертити, сделав 51 пластическую операцию. К переменам женщину подвигли видения, где ей отводилась роль царицы Древнего Египта.
-
Вторник, 16 октября 2012 годаНедавно 31-летний Гоген Солнцев, человек, к которому намертво приклеился ярлык «самый известный фрик России», сделал очередную пластическую операцию. И, судя по всему, неудачную.
-
Понедельник, 8 октября 2012 годаВэнити Уандер прославилась благодаря своей «пятой точке». Она является обладательницей самой большой попы в мире.
-
Вторник, 14 августа 2012 годаЧто означает статус OFF для пластического хирурга? Как можно сменить его на VIP? Кто такие OFF-топовые пластические хирурги?
-
Понедельник, 23 июля 2012 годаУ 1-2% населения Земли обнаружен опасный синдром — дисморфофобия. Кто может помочь этой категории людей избавиться от бремени комплексов: психолог или пластический хирург?
-
Понедельник, 25 июня 2012 годаРинопластику можно сделать у любого хирурга и в любой клинике, но ее нужно делать там, где Вашей красоте и здоровью ничего не угрожает.